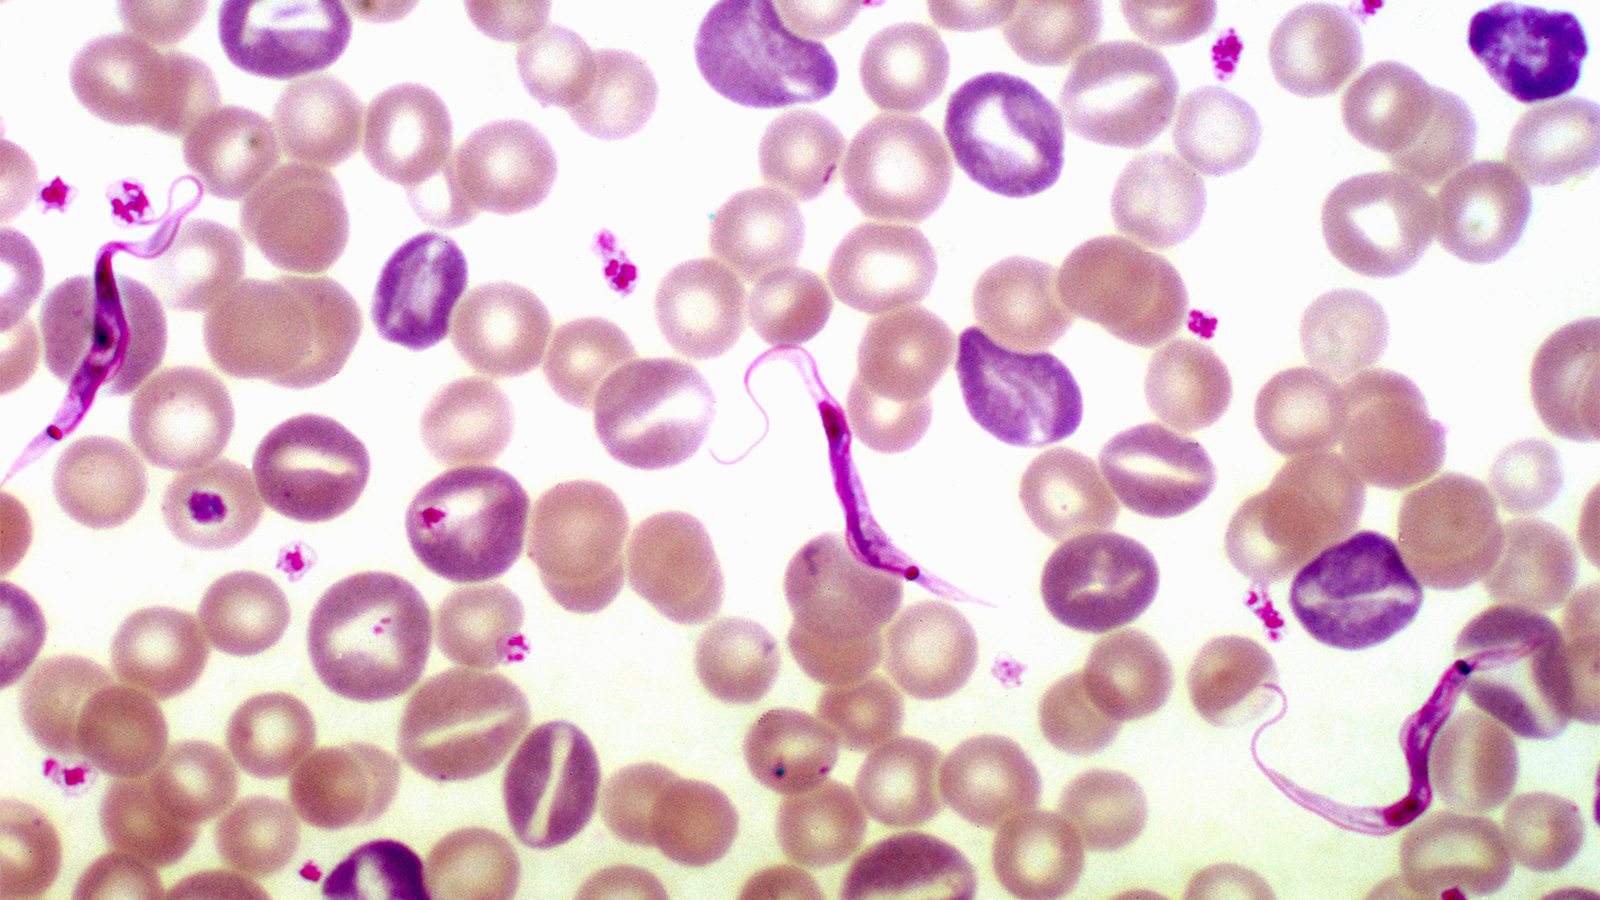

Treating the Tsetse’s Curse
(MedPage Today) — On March 20, 1990, a previously healthy man returned to the U.S. after a 10-day safari in Kenya, Tanzania, and Rwanda. He was in my hospital’s emergency department just 6 days later with a fever of 104, a magenta nodule on his…
(MedPage Today) — On March 20, 1990, a previously healthy man returned to the U.S. after a 10-day safari in Kenya, Tanzania, and Rwanda. He was in my hospital’s emergency department just 6 days later with a fever of 104, a magenta nodule on his…
Powered by WPeMatico
